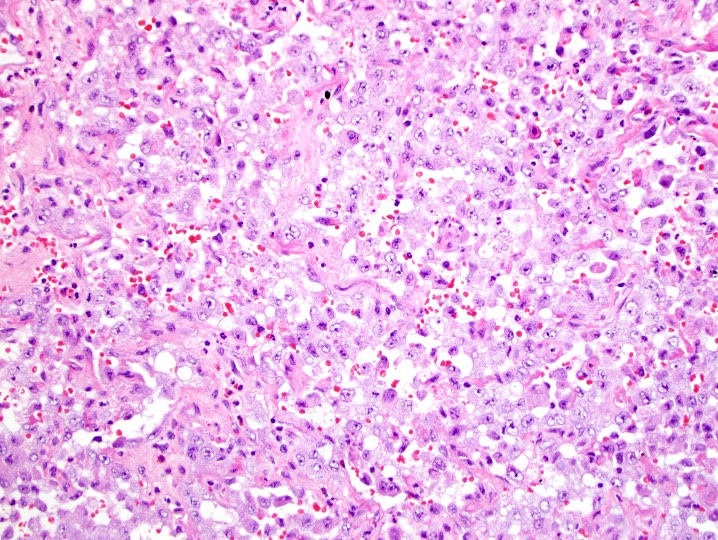
Nooshin_Dashti's tweet image. Destructive femur mass. Bx: CD31 and FLI-1. Note the epi morph. #BSTP

#bstp search results
We just kicked off the #BSTP — the Brain Science Training Program — with the Class of 2025–2026, a group of young & hopeful students! Over the next 10 months, let’s enjoy the journey of exploring the wide and deep world of #neuroscience together with CBS researchers! #riken #STEM

I will be presenting a lecture on multi-scale computation in the human brain at the Brain Science Training Program (#脳科学塾, #BSTP) on April 25th.

⏳ Just 1 week to go until #BSTP #ESTP Congress 2025 in Manchester! Meet the Patholytix team & catch Colin Doolan’s talk “Patholytix: Beyond Drug Safety” on Sept 24, 13:30-14:00. Book a meeting: eu1.hubs.ly/H0n5RQB0

Attention graduate students residing in Japan❗️ The Brain Science Training Program #BSTP is now accepting applications. Hear from those who just completed the 2023-2024 program and see if it's right for you. Apply now▶️cbs.riken.jp/en/TP/ #neuroscience #riken #onlinestudy
For young scientists interested in #neuroscience but with limited opportunities: Apply for #BSTP, a 9-month lecture series to explore neuroscience and build knowledge from basic to advanced. Application deadline: 4 days away❗️ ▶️▶️cbs.riken.jp/en/TP/

Day 2 of #ESTP/#BSTP is underway in Manchester. We're at booth 9 demoing Patholytix & Foresight, digital pathology for tox & research at scale. Don't miss Colin Doolan’s talk at 13:30 today: “Beyond Drug Safety” #ToxPathManchester2025 #ESTP2025




Le siège flambant neuf de la BSTP sera bientôt prêt ! Un grand merci à mon équipe pour leur suivi rigoureux. Hâte de vous accueillir dans nos nouveaux locaux pour mieux vous servir ! #BSTP




Alongside the #CBS_Summer, we offer #BSTP, a 10-month program to explore #neuroscience and build networks. Learn more in "Neuroscience in Action: My Journey Across Finance, IT, and AI," a new report from a program alumnus now an independent researcher! 🔗 cbs.riken.jp/en/articles/bs…

Fresh report from a #BSTP graduate! “Foundations & Frontiers: How RIKEN and Peers Catalyzed My Path to Curing the Incurable” Everyone joins with different goals — it’s up to you to make the most of the program and build lasting connections🫵 🧠Full story: cbs.riken.jp/en/articles/bs…

Congratulations on completing the RIKEN CBS Brain Science Training Program #BSTP 2024–2025🎉 Your passion and dedication to #neuroscience will continue to inspire progress. Thank you for being part of the program, and best wishes for your scientific journey! #STEM #脳科学塾

Hiroki Tokizaki, an undergrad from Saitama University, just completed the 9-month Brain Science Training Program (#BSTP) and joined #cbs_summer. Initially focused on marine biology, he is now set on a career in neuroscience. #riken #Neuroscience #STEM

That’s a wrap on Day 3 of #ESTP/#BSTP. Great conversations, a strong session from Colin Doolan yesterday, and an evening drinks reception to close it out. The team will be at tonight’s gala dinner, come say hello if you’re attending! #ToxPathManchester2025 #ESTP2025



A key component of the #3RCReWS Project is the #upgrades to the Bridgetown Sewage Treatment Plant #BSTP. #3RCReWSBarbados #waterislife #CCCCC #BWA #Dahlem #TeknikStruktur #climateresilience #climateaction #waterforall #climatechangeimpacts #treatmentfacility #Barbados
Les Femmes de la BSTP font la différence ! En pilotant nos programmes gender, elles aident à réduire la vulnérabilité économique et augmentent les revenus des femmes. #BSTP #genderequality #March8

We just kicked off the #BSTP — the Brain Science Training Program — with the Class of 2025–2026, a group of young & hopeful students! Over the next 10 months, let’s enjoy the journey of exploring the wide and deep world of #neuroscience together with CBS researchers! #riken #STEM

That’s a wrap on Day 3 of #ESTP/#BSTP. Great conversations, a strong session from Colin Doolan yesterday, and an evening drinks reception to close it out. The team will be at tonight’s gala dinner, come say hello if you’re attending! #ToxPathManchester2025 #ESTP2025



Day 2 of #ESTP/#BSTP is underway in Manchester. We're at booth 9 demoing Patholytix & Foresight, digital pathology for tox & research at scale. Don't miss Colin Doolan’s talk at 13:30 today: “Beyond Drug Safety” #ToxPathManchester2025 #ESTP2025




⏳ Just 1 week to go until #BSTP #ESTP Congress 2025 in Manchester! Meet the Patholytix team & catch Colin Doolan’s talk “Patholytix: Beyond Drug Safety” on Sept 24, 13:30-14:00. Book a meeting: eu1.hubs.ly/H0n5RQB0

Nouvelle publication : L'Écho des Marchés du 17-09-2025 est disponible ! 📢 Trouvez les dernières opportunités en #Cameroun pour la construction, les travaux publics et l'électrification. #BSTP #AppelOffres urlr.me/kWqX9f
Dear young neuroscientists, Thank you very much for applying to the next #BSTP! The application for the upcoming term starting in October is now closed. We will contact you soon regarding the selection results and provide details for those who will join the program🧠
For young scientists interested in #neuroscience but with limited opportunities: Apply for #BSTP, a 9-month lecture series to explore neuroscience and build knowledge from basic to advanced. Application deadline: 4 days away❗️ ▶️▶️cbs.riken.jp/en/TP/

We’re attending BSTP-ESTP Congress 2025! Join us in Manchester Sep 23-26 to explore how Patholytix is the complete pathology ecosystem for research pathology. See you there! #BSTP #ESTP

Promotion du contenu local ! La BSTP a organisé le BSTPLinkUp pour connecter les PME guinéennes aux grandes entreprises. En collaboration avec @EnabelGuinee , cet événement a permis de créer des partenariats cet d’ouvrir des opportunités de sous-traitance. #BSTP #Enabel #PME




Fresh report from a #BSTP graduate! “Foundations & Frontiers: How RIKEN and Peers Catalyzed My Path to Curing the Incurable” Everyone joins with different goals — it’s up to you to make the most of the program and build lasting connections🫵 🧠Full story: cbs.riken.jp/en/articles/bs…

⚠️ Appel d’offres⚠️ Appel à Manifestation d’Intérêt (AMI) pour les services de voyage et d’hébergement de la CTG - E0010. Date de clôture : 07 Juillet Comment s’inscrire ? ☎️ 625-63-21-77 🌏bstpgn.com 🏠 Dans nos locaux à la Minière #BSTP #ContenuLocal

Congratulations on completing the RIKEN CBS Brain Science Training Program #BSTP 2024–2025🎉 Your passion and dedication to #neuroscience will continue to inspire progress. Thank you for being part of the program, and best wishes for your scientific journey! #STEM #脳科学塾

🌍 WEBINAIRE EXCLUSIF : Opportunités d’affaires et d’investissement en Guinée pour les entreprises turques ! 📅 Date :26 Mars 2025 ⏰ Heure :14h00 - 16h00 (GMT) Rejoignez-nous pour une session riche en insights sur : us02web.zoom.us/w/89611877287?… #InvestirEnGuinée #Turquie #BSTP

⚠️Appel d’offres⚠️ AVIS À MANIFESTATION D'INTÉRÊT - SERVICES DE SOUTIEN À LA FABRICATION DE TUYAUX HYDRAULIQUES - PROJET SIMANDOU *Comment s’inscrire ? * ☎625-63-21-77 🌍 bstpgn.com 🏚 Dans nos locaux à la Minière #BSTP #ContenuLocal #RioTintoSimfer

Alongside the #CBS_Summer, we offer #BSTP, a 10-month program to explore #neuroscience and build networks. Learn more in "Neuroscience in Action: My Journey Across Finance, IT, and AI," a new report from a program alumnus now an independent researcher! 🔗 cbs.riken.jp/en/articles/bs…

𝐄𝐱𝐜𝐞𝐥𝐥𝐞𝐧𝐭 𝐝𝐞́𝐛𝐮𝐭 𝐝𝐞 𝐬𝐞𝐦𝐚𝐢𝐧𝐞! Que cette semaine soit riche en opportunités et partenariats fructueux. Ensemble, continuons à bâtir des connexions solides pour faire rayonner nos entreprises et renforcer le tissu économique local. #BSTP #BonDébutDeSemaine

13ᵉ et 14ᵉ sessions du Conseil d’administration de la BSTP Pour en savoir plus, cliquez ici : BSTP : africaguinee.com/bstp-le-consei… #BSTP #ContenuLocal #CA2024




Rejoignez-nous le 29 novembre pour une journée de panels stratégiques et d’opportunités entrepreneuriales ! 🚀 📍 Lieu : Dream For Africa 📥 Inscrivez-vous dès maintenant : forms.gle/vBcyHhMmuQnkdn… #DreamersNET2024 #EntrepreneuriatGuinéen #BSTP #Opportunités #Innovation




We just kicked off the #BSTP — the Brain Science Training Program — with the Class of 2025–2026, a group of young & hopeful students! Over the next 10 months, let’s enjoy the journey of exploring the wide and deep world of #neuroscience together with CBS researchers! #riken #STEM

For young scientists interested in #neuroscience but with limited opportunities: Apply for #BSTP, a 9-month lecture series to explore neuroscience and build knowledge from basic to advanced. Application deadline: 4 days away❗️ ▶️▶️cbs.riken.jp/en/TP/

I will be presenting a lecture on multi-scale computation in the human brain at the Brain Science Training Program (#脳科学塾, #BSTP) on April 25th.

⏳ Just 1 week to go until #BSTP #ESTP Congress 2025 in Manchester! Meet the Patholytix team & catch Colin Doolan’s talk “Patholytix: Beyond Drug Safety” on Sept 24, 13:30-14:00. Book a meeting: eu1.hubs.ly/H0n5RQB0

CBS 脳科学塾(BSTP)締め切り迫る! 今週日曜日(9/10)まで受付中 Learn and discuss together! The application deadline for #BSTP is Sunday, September 10. #脳科学塾 #BSTP cbs.riken.jp/en/TP/applying…

#BSTP is off to an exciting start with 26 online/onsite participants from all over Japan, primarily from Tokyo. Over the next 9 months, CBS PIs will lead them through diverse #neuroscience areas, and our journal club will foster candid discussions with CBS researchers.

Day 2 of #ESTP/#BSTP is underway in Manchester. We're at booth 9 demoing Patholytix & Foresight, digital pathology for tox & research at scale. Don't miss Colin Doolan’s talk at 13:30 today: “Beyond Drug Safety” #ToxPathManchester2025 #ESTP2025




10月開催理研CBS脳科学塾 ただいま申し込み受付中! 脳神経科学を広く学べるチャンス! You will be amazed at the wide range of neuroscience topics you can learn in 9 months! APPLY HERE 👉cbs.riken.jp/en/TP/applying… Check the BSTP Alumni Stories 👉cbs.riken.jp/en/articles/01… #BSTP #脳科学塾

Lipoblastoma-like tumor. Shout out to JKS. #BSTP #gyn pubmed.ncbi.nlm.nih.gov/29976943/ pubmed.ncbi.nlm.nih.gov/37307874/



That’s a wrap on Day 3 of #ESTP/#BSTP. Great conversations, a strong session from Colin Doolan yesterday, and an evening drinks reception to close it out. The team will be at tonight’s gala dinner, come say hello if you’re attending! #ToxPathManchester2025 #ESTP2025



Alongside the #CBS_Summer, we offer #BSTP, a 10-month program to explore #neuroscience and build networks. Learn more in "Neuroscience in Action: My Journey Across Finance, IT, and AI," a new report from a program alumnus now an independent researcher! 🔗 cbs.riken.jp/en/articles/bs…

La caravane de la sous-traitance est officiellement lancée dans le corridor Simandou, en collaboration avec Rio Tinto et le consortium Winning. 🌍💼 Merci Faranah pour la mobilisation #bstp #Simandou


A l'occasion de la Journée internationale du Travail, la Bourse de Sous-Traitance et de Partenariats (BSTP) souhaite une bonne fête du travail aux travailleurs de Guinée et du monde entier. #BSTP #ContenuLocal

#WomensHistoryMonth celebrations recognize those who support the teams from the #BridgetownSewageTreatmentPlant (#BSTP) and the #SouthCoastSewageTreatmentPlant (#SCSTP) of the #BWA. We honour your awesome contributions and service! #wastewaterdivision #3RCReWS #waterislife

#Dahlem Consultants, along with local consultants #TeknikStruktur and @BWA representatives, led by Project Manager, Mrs. Shelley Parris, at the start of the tour of the Bridgetown Sewage Treatment Plant (#BSTP) on March 7, 2024. #3RCReWSBarbados #waterislife #BSTPupgrade

Hiroki Tokizaki, an undergrad from Saitama University, just completed the 9-month Brain Science Training Program (#BSTP) and joined #cbs_summer. Initially focused on marine biology, he is now set on a career in neuroscience. #riken #Neuroscience #STEM

Something went wrong.
Something went wrong.
United States Trends
- 1. #WWERaw 71.1K posts
- 2. Purdy 27.6K posts
- 3. Panthers 37.2K posts
- 4. Bryce 20.7K posts
- 5. Finch 14.1K posts
- 6. Timberwolves 3,601 posts
- 7. 49ers 40.7K posts
- 8. Canales 13.3K posts
- 9. Gonzaga 3,861 posts
- 10. Keegan Murray 1,272 posts
- 11. #FTTB 5,698 posts
- 12. Penta 10.4K posts
- 13. Mac Jones 4,907 posts
- 14. Niners 5,726 posts
- 15. Zags N/A
- 16. Amen Thompson 2,017 posts
- 17. #KeepPounding 5,333 posts
- 18. Gunther 15K posts
- 19. Malik Monk N/A
- 20. Streaming 2.0 2,197 posts